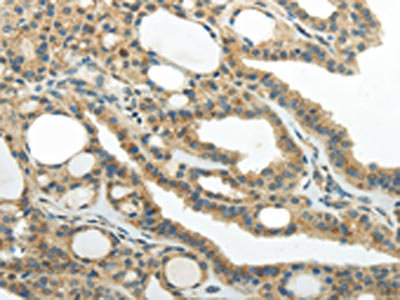

SMYD2 Antibody
-
中文名稱:SMYD2兔多克隆抗體
-
貨號(hào):CSB-PA153500
-
規(guī)格:¥1100
-
圖片:
-
The image on the left is immunohistochemistry of paraffin-embedded Human thyroid cancer tissue using CSB-PA153500(SMYD2 Antibody) at dilution 1/30, on the right is treated with synthetic peptide. (Original magnification: ×200)
-
The image on the left is immunohistochemistry of paraffin-embedded Human esophagus cancer tissue using CSB-PA153500(SMYD2 Antibody) at dilution 1/30, on the right is treated with synthetic peptide. (Original magnification: ×200)
-
-
其他:
產(chǎn)品詳情
-
Uniprot No.:
-
基因名:SMYD2
-
別名:Histone methyltransferase SMYD2 antibody; HSKM B antibody; HSKM-B antibody; HSKMB antibody; KMT3C antibody; Lysine N-methyltransferase 3C antibody; MGC119305 antibody; N lysine methyltransferase SMYD2 antibody; N-lysine methyltransferase SMYD2 antibody; SET and MYND domain containing 2 antibody; SET and MYND domain containing protein 2 antibody; SET and MYND domain-containing protein 2 antibody; Smyd2 antibody; SMYD2_HUMAN antibody; Zinc finger MYND domain containing 14 antibody; ZMYND14 antibody
-
宿主:Rabbit
-
反應(yīng)種屬:Human,Mouse,Rat
-
免疫原:Synthetic peptide of Human SMYD2
-
免疫原種屬:Homo sapiens (Human)
-
標(biāo)記方式:Non-conjugated
-
抗體亞型:IgG
-
純化方式:Antigen affinity purification
-
濃度:It differs from different batches. Please contact us to confirm it.
-
保存緩沖液:-20°C, pH7.4 PBS, 0.05% NaN3, 40% Glycerol
-
產(chǎn)品提供形式:Liquid
-
應(yīng)用范圍:ELISA,IHC
-
推薦稀釋比:
Application Recommended Dilution ELISA 1:2000-1:5000 IHC 1:25-1:100 -
Protocols:
-
儲(chǔ)存條件:Upon receipt, store at -20°C or -80°C. Avoid repeated freeze.
-
貨期:Basically, we can dispatch the products out in 1-3 working days after receiving your orders. Delivery time maybe differs from different purchasing way or location, please kindly consult your local distributors for specific delivery time.
-
用途:For Research Use Only. Not for use in diagnostic or therapeutic procedures.
相關(guān)產(chǎn)品
靶點(diǎn)詳情
-
功能:Protein-lysine N-methyltransferase that methylates both histones and non-histone proteins, including p53/TP53 and RB1. Specifically trimethylates histone H3 'Lys-4' (H3K4me3) in vivo. The activity requires interaction with HSP90alpha. Shows even higher methyltransferase activity on p53/TP53. Monomethylates 'Lys-370' of p53/TP53, leading to decreased DNA-binding activity and subsequent transcriptional regulation activity of p53/TP53. Monomethylates RB1 at 'Lys-860'.
-
基因功能參考文獻(xiàn):
- We show that tool compounds as well as CRISPR/Cas9 fail to reproduce many of the cell proliferation findings associated with SMYD2 and SMYD3 inhibition previously obtained with RNAi based approaches and with early stage chemical probes. PMID: 29856759
- Lysine methylation represses p53 activity in teratocarcinoma cancer cells via up-regulation of SMYD2 and PR-Set7 and perpetuation of cancer cells proliferation. PMID: 27535933
- SMYD2-H4K20me1-L3MBTL1 axis contributes to HIV-1 latency and can be targeted with small-molecule SMYD2 inhibitors. PMID: 28494238
- identifie novel cellular substrates of the lysine methyltransferase SMYD2. Of the 14 novel putative SMYD2 substrates identified, six were confirmed in cells by immunoprecipitation: MAPT, CCAR2, EEF2, NCOA3, STUB1, and UTP14A. Treatment with the selective SMYD2 inhibitor BAY-598 abrogated the methylation signal, indicating that methylation of these novel substrates was dependent on the catalytic activity of SMYD2 PMID: 27163177
- The SMYD2 may promote BMP signaling by directly methylating BMPR2, which, in turn, stimulates BMPR2 kinase activity and activation of the BMP pathway. PMID: 28588028
- Knockdown of SMYD2 as well as treatment with a SMYD2 inhibitor in two NSCLC cell lines with an EML4-ALK gene significantly attenuated the phosphorylation levels of the EML4-ALK protein. PMID: 28370702
- SMYD2 knockdown confers relative resistance to human AML cells against multiple classes of DNA damaging agents. PMID: 28187429
- Substrate crevices of Smyd2 and Smyd3 show distinct features in terms of spatial, hydration, and electrostatic properties that emphasize their characteristic modes of substrates interaction and entry pathways for inhibitor binding. PMID: 27959541
- High expression of SMYD2 is associated with chronic lymphocytic leukemia. PMID: 26790435
- Study reveals a collection of 10 enriched sequence motifs in Kme1 sites that were identified upon SMYD2 overexpression which were also downregulated in response to SMYD2 knockdown. These findings suggest that these motifs reflect the substrate specificity of SMYD2 in esophageal squamous cell carcinoma cell line. PMID: 26750096
- Results show that high expression levels of SMYD2, SETD3, and NO66 in renal cell tumors. Their low expression levels were significantly associated with shorter disease-specific and disease-free survival. PMID: 26488939
- Suggest that SMYD2 plays a role in tumor progression and might be a useful prognosticator in HPV-unrelated, nonmultiple head and neck squamous cell carcinomas. PMID: 26826421
- SMYD2-mediated methylation negatively regulates PTEN tumor suppressor activity and results in activation of the phosphatidylinositol 3-kinase-AKT pathway. PMID: 25925379
- Comprehensive motif-based searches and mutational analysis further established four additional substrates of SMYD2. PMID: 25533488
- in addition to esophageal squamous cell carcinoma, SMYD2 is also amplified and/or overexpressed in breast and liver primary tumors PMID: 25825497
- a novel mechanism of PARP1 in human cancer through its methylation by SMYD2 PMID: 24726141
- SMYD2 has a crucial role in tumor cell proliferation by its overexpression and highlight its usefulness as a prognostic factor and potential therapeutic target in gastric cancer. PMID: 25321194
- Data indicate that irect estrogen receptor alpha (ERalpha) methylation by histone methyltransferase SMYD2 regulates estrogen signaling. PMID: 24594358
- A novel mechanism for human carcinogenesis via methylation of HSP90AB1 by SMYD2. PMID: 24880080
- SMYD2 expression is altered in acute lymphoblastic leukemia bone marrow samples and its high expression was correlated with a bad prognosis. Moreover, SMYD2 expression level significantly decreases in patients that respond to chemotherapy treatment. PMID: 24631370
- Findings suggest that SMYD2 (SET and MYND domain containing protein 2), a histone lysine methyltransferase, in embryonic stem (ES) cell differentiation. PMID: 23873367
- Data suggest that SMYD2-mediated estrogen receptor alpha (ERalpha) protein methylation and p300/cAMP response element-binding protein-binding protein-dependent ERalpha acetylation play an important role in the estrogen-induced gene expression profiles. PMID: 24101509
- -dependent RB1 methylation at lysine 810 promotes cell cycle progression of cancer cells. Further study may explore SMYD2-dependent RB1 methylation as a potential therapeutic target in human cancer. PMID: 22787429
- Data report the crystal structure of the full-length human Smyd2 in complex with S-adenosyl-L-homocysteine (AdoHcy). PMID: 21724641
- Data highlights the ability of SMYD proteins to form unique protein complexes that may underlie their various biological functions and the SMYD2-mediated methylation of the key molecular chaperone HSP90. PMID: 22028380
- SMYD2 has a role in specifically recognizing and regulating functions of p53 tumor suppressor through Lys-370 monomethylation PMID: 21880715
- Structural basis of substrate methylation and inhibition of SMYD2 PMID: 21782458
- Substrate specificity and product analysis studies established SMYD2 as a monomethyltransferase that prefers nonmethylated p53 peptide substrate. PMID: 21678921
- SMYD2 gene expression is decreased in both classic and follicular variants of papillary thyroid carcinoma. PMID: 21509594
- RB monomethylation at lysine 860 by SMYD2 provides a direct binding site for L3MBTL1. PMID: 20870719
- The combination of the SMYD2 interactome with the gene expression data suggests that some of the genes regulated by SMYD2 are closely associated with SMYD2-interacting proteins. PMID: 18065756
- SMYD2 plays an important role in tumor cell proliferation through its activation/overexpression and highlight its usefulness as a prognosticator and potential therapeutic target in ESCC. PMID: 19423649
顯示更多
收起更多
-
亞細(xì)胞定位:Cytoplasm, cytosol. Nucleus.
-
蛋白家族:Class V-like SAM-binding methyltransferase superfamily
-
數(shù)據(jù)庫鏈接:
Most popular with customers
-
-
YWHAB Recombinant Monoclonal Antibody
Applications: ELISA, WB, IHC, IF, FC
Species Reactivity: Human, Mouse, Rat
-
Phospho-YAP1 (S127) Recombinant Monoclonal Antibody
Applications: ELISA, WB, IHC
Species Reactivity: Human
-
-
-
-
-